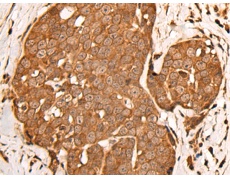
一抗

中文名稱 : 兔抗ZPR1多克隆抗體
|
Background: |
ZPR1 is a zinc finger-containing protein that is capable of binding to the intracellular tyrosine kinase domain of the epidermal growth factor receptor. Stimulation of mammalian cells with epidermal growth factor reduces ZPR1 affinity for the EGFR and leads to an accumulation of the protein in the nucleus. The ZPR1 zinc finger is necessary for its association with the EGFR. |
|
Applications: |
ELISA, WB, IHC |
|
Name of antibody: |
ZPR1 |
|
Immunogen: |
Synthetic peptide of human ZPR1 |
|
Full name: |
ZPR1 zinc finger |
|
Synonyms: |
ZNF259 |
|
SwissProt: |
O75312 |
|
ELISA Recommended dilution: |
2000-5000 |
|
IHC positive control: |
Human prostate cancer and Human esophagus cancer |
|
IHC Recommend dilution: |
25-100 |
|
WB Predicted band size: |
51 kDa |
|
WB Positive control: |
Human liver cancer tissue |
|
WB Recommended dilution: |
500-2000 |


 購物車
購物車 幫助
幫助
 021-54845833/15800441009
021-54845833/15800441009